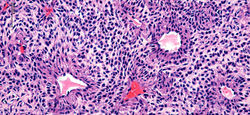
F5

CASO 119
13 de diciembre
Dr. Reinhard Rodríguez y Dra. Vanessa García Valencia. Residentes Dermatopatología, Universidad CES. Dra. Camila Montoya. Patóloga- Dermatopatóloga. MSPBS. Asunción, Paraguay.
Hombre, 30 años, múltiples pápulas asintomáticas, color piel, de 0,4 cc en el pecho. Sin antecedentes familiares.
¿Cuál cree usted es el diagnóstico más probable?
A. Esteatocistoma múltiple
B. Nevus del folículo piloso
C. Siringomas
D. Quiste velloso eruptivo
Solución y cierre del caso 23 de diciembre
CASO 112 (1ra y 2da parte)
3 de Mayo
Dra. Camila Montoya. Patóloga-Dermatopatóloga. Asunción, Paraguay. Dr. Rodrigo Restrepo. Patólogo-Dermatopatólogo. Profesor Programa de Especialización en Dermatopatología. Universidad CES. Medellín, Colombia.
Caso cortesía Dra. Ana María Aristizabal. Dermatológa. Profesora Univerdidad CES, Mdlln, Colombia.
Niña, 13 años. Áreas alopécicas fronto temporo parietales. Se tomaron dos grupos de biopsias en momentos diferentes (F1 primero; F2, F3 y F4 meses después)
Con los hallazgos histológicos ¿cuál cree es el diagnóstico más probable?
A. Alopecia androgénica
B. Alopecia frontal fibrosante
C. Alopecia areata en patrón ofiásico
D. Alopecia por tracción
Fotos clínicas 8 de mayo
Solución y cierre del caso 18 de mayo
![]() F1 | ![]() F2 | ![]() F3 |
|---|---|---|
![]() F4 | ![]() F5 |
CASO 120
18 de enero
Dr. Reinhard Rodríguez y Dr. Javier Hernández. Residentes Dermatopatología, Universidad CES. Dra. Camila Montoya. Patóloga- Dermatopatóloga. MSPBS. Asunción, Paraguay.
Caso y fotos clínicas cortesía Dra. Carolina Velásquez. Profesora Dermatología Universidad CES. Mdlln, Col
Paciente masculino de 85 años quien presenta mácula hiperpigmentada en la frente.
¿Cuál cree usted es el diagnóstico más probable?
A. Queratosis actínica pigmentada
B. Lentigo solar
C. Nevus displásico
D. Lentigo maligno
Solución y cierre del caso 30 de enero
CASO 119
13 de diciembre
Dr. Reinhard Rodríguez y Dra. Vanessa García Valencia. Residentes Dermatopatología, Universidad CES. Dra. Camila Montoya. Patóloga- Dermatopatóloga. MSPBS. Asunción, Paraguay.
Hombre, 30 años, múltiples pápulas asintomáticas, color piel, de 0,4 cc en el pecho. Sin antecedentes familiares.
¿Cuál cree usted es el diagnóstico más probable?
A. Esteatocistoma múltiple
B. Nevus del folículo piloso
C. Siringomas
D. Quiste velloso eruptivo
Solución y cierre del caso 23 de diciembre
Si no te has inscrito, para opinar debes unirte a nuestra lista de correo AQUí
ESTACIÓN PIEL
Programa de Especialización en Dermatopatología
Universidad CES
Si no te has inscrito aún, para opinar debes unirte a nuestra lista de correo AQUí
CASO 132 (2da parte H&E)
25 de noviembre
Dra. Vanessa García Valencia / Dr. Reinhard Rodríguez Schotborgh Residentes de Dermatopatología Universidad CES. Dra. Camila Montoya. Profesora Universidad CES. Patóloga-Dermatopatóloga. MSPBS. Asunción, Paraguay. Caso cortesía Dra. Laura Jaramillo Dermatóloga Universidad CES. Medellín, Colombia.
Hombre de 53 años. Pápula única, dolorosa, de superficie lisa en brazo izquierdo.
Con los hallazgos clínicos y microscópicos con tinción de H&E e inmunohistoquímica ¿cuál cree ahoraes el diagnóstico más apropiado?:
A. Espiradenoma
B. Tumor glómico
C. Leiomioma
D. Neurofibroma
2da parte Inmunohistoquímica 1 de diciembre. Solución y cierre del caso 6 de diciembre
![]() F1 | ![]() F2 | ![]() F3 |
|---|---|---|
![]() F4 | ![]() F5 | ![]() F6 ACTINA DE MÚSCULO LISO |
![]() F7 CD34 |
Si no te has inscrito aún, para opinar debes unirte a nuestra lista de correo AQUí
Respuestas
Tumor glómico Carlos Barria
Tumor glómico María Gloria Mendoza
Tumor glómico Camilo Andrés Pérez Montiel
Tumor glómico María del Mar Lorido
Tumor glómico María Gaona
Tumor glómico Sonia Tello
Tumor glómico Elena Gallego
Tumor glómico Marcela Olaya
Tumor glómico Aloisio Carlos Gamonal
Tumor glómico Gustavo Antonio Posso García
Espiradenoma Rolando Hernández Pérez
Tumor glómico Elizabeth Ball de Picón
Tumor glómico Lina Huérfano
Tumor glómico Carlos Cortés Caballero
Tumor glómico Francisco Javier Merino
Tumor glómico Rina Liliana Luna
Lesión dérmica no encapsulado de células uniformes redondas peri vasculares
Tumor glómico Verónica Lizeth González
Tumor glómico Aleydi Gómez
Tumor glómico Paola Prieto Pérez
Tumor glómico Libia Jiménez
Tumor glómico Guimar Jiménez
Tumor glómico Ana Cock
Respuestas 2da parte - H&E/IHQ
Tumor glómico Xiomy Cuadros
Tumor glómico Lina Huérfano
Tumor glómico Guimar Jiménez
Leiomioma Adriana Balza Haddad
Tumor glómico Sonia Tello Tello
Tumor glómico Paola Prieto Pérez
Tumor glómico Beatriz di Martino
Tumor glómico Nancy Grandez
Tumor glómico Ruth Mabel Vergara
Tumor glómico Camilo Andrés Pérez Montiel
Tumor glómico Julia Mesa
Tumor glómico Mayra Carrijo
Tumor glómico Paola Yolotzin
Tumor glómico Paulina Garcés
Tumor glómico Lizza Paz
Tumor glómico Mary Escarabay
Tumor glómico Patricia Reyes
Tumor glómico Carmen Camauta
Tumor glómico Ana Cock
Espiradenoma Anónimo
Tumor glómico Alberto Alvarado
Tumor glómico Eduwiges Martínez
Tumor glómico Valeria Ureña
Tumor glómico Erika Stephania Alvarado Arana
Tumor glómico María del Conuelo Gómez
Respuesta
B. Tumor Glómico (correcta)
Descrito originalmente por Hoyer en 1877 y caracterizado formalmente por Masson en 1924, corresponde a una neoplasia mesenquimal infrecuente a nivel cutáneo perteneciente a la familia de los paragangliomas(1). Esta neoplasia se compone de células musculares lisas especializadas que forman el cuerpo glómico, una estructura termorreguladora y quimosensible que genera una anastomosis arteriovenosa localizada en sitios acrales y en la piel de la región precoccigea(1,2). Esta lesión se relaciona con sus homólogos originados a nivel de los cuerpos carotideos, yugular y timpánico, recibiendo múltiples denominaciones a lo largo de la historia (quemodectoma no cromafín, paraganglioma)(2).
Clínicamente se trata de una lesión tumoral dérmica con la triada clásica de dolor intenso desproporcionado, sensibilidad localizada y sensibilidad al frio(1,3). Se presenta como una lesión única, que rara vez supera un centímetro de diámetro, muy frecuente a nivel subungular o en la dermis palmar, antebrazo y plantar. La presentación subungular es muy frecuente en mujeres, no siendo el caso para localizaciones extradigitales donde no hay predilección por sexo. Cerca del 70% de los casos se presentan en pacientes menores de 30 años(1). Adicionalmente se han descrito tumores glómicos en diversas localizaciones (incluso donde no se espera la presencia de cuerpos glómicos)(4), así como la presentación de lesiones múltiples con un componente hereditario(3).
Histológicamente corresponde a una neoplasia mesenquimal compuesta por tres elementos: células glómicas, vasos sanguíneos y células musculares lisas convencionales(1,5). La proporción de estos componentes ha dado origen a la clasificación morfológica de tumor glómico sólido (con escasa vasculatura y músculo liso), glomangioma (con prominente componente vascular) como en este caso y glomangiomioma (con predominio tanto de componente vascular como muscular liso)(1). La forma de tumor glómico sólido es la más frecuente encontrada, seguido por los glomangiomas y los raros glomangiomiomas.
Generalmente se describen como una lesión compuesta por vasos ramificados tapizados por células endoteliales sin atipias, separados por una población de células redondas de núcleo central (generalmente con pseudoinclusión) y citoplasma eosinófilo, dispuestas formando nidos, sábanas o trabéculas, presentando una distribución perivascular muy característica(F5). Estas células presentan bordes nítidos, descansando sobre una matriz hialina(F4), no siendo raro encontrar incluso depósitos de mucina(1,5). La lesión se localiza a nivel dérmico(F1), con bordes definidos, no encapsulada, generalmente relacionada con un vaso sanguíneo o una red vascular fácilmente identificable(F2-3)(1). Pese a su aspecto epitelioide y su íntima relación con la vasculatura, estas células son positivas para marcadores musculares como AML(F6), H-caldesmon o calponina, sin expresión de marcadores epiteliales. Los marcadores endoteliales como CD34(F7), CD31, ERG, resaltan el componente endotelial que coexiste con la lesión(1,4,5).
Su comportamiento es benigno, siendo la resección quirúrgica curativa. Se debe prestar atención a características atípicas como cambios nucleares, patrón pericitoide, elevado índice mitótico y necrosis, ya que se han relacionado con un comportamiento más agresivo como invasión y metástasis(5).
A. Espiradenoma (incorrecto): Rara vez los espiradenomas exhiben una vasculatura prominente, despertando el diagnóstico diferencial con el tumor glómico. Esta duda se resuelve demostrando la diferenciación ductal y apoyándose en marcadores epiteliales para el diagnóstico diferencial. Ver CASO 46
C. Leiomioma (incorrecto): Este tumor se distingue del tumor glómico por la ausencia de componente glómico (células redondas con pseudoinclusiones y disposición perivascular). Aunque existe cierto solapamieto entre las lesiones derivadas de músculo liso, los tumores glómicos y los tumores miopericíticos, generalmente estas dudas se resuelven fácilmente con la correlación clínica y las características microscópicas. La inmunohistoquímica en estos casos es no contributiva. Ver CASO 16
D. Neurofibroma (incorrecto): Pueden corresponder a un diferencial si se trata de una forma de tumor glómico con prominente población de células fusiformes que descansen en una matriz mixoide. Se distingue fácilmente del tumor glómico por la ausencia de vasos prominentes relacionados con el tumor, así como por la ausencia de positividad para marcadores musculares.
Bibliografía:
-
Gombos Z, Zhang P. Glomus Tumor. Archives of Pathology & Laboratory Medicine. 2008;132(9):1448-1452. Free text link
-
Ruben R. The history of the glomus tumors – nonchromaffim chemodectoma: a glimpse of biomedical Camelot. Acta Oto-Laryngologica. 2007;127(4):411-416. PubMed
-
Joseph VM, Maryada VR, Venkata GR, et al. Bilateral Solitary Glomus Tumour of Thumb: A Case Report. J Clin Diagn Res. 2017 May;11(5):RD04-RD06. Free text link
-
Alyaseen HN, Al Ghadeer HA, Al-Ghanim ME, et al. Extradigital Glomangioma of the Cutaneous Chest Wall. Cureus. 2021 Sep 12;13(9):e17910. Free text link
-
Luzar B, Martin B, Fisher C, Calonje E. Cutaneous malignant glomus tumours: applicability of currently established malignancy criteria for tumours occurring in the skin. Pathology. 2018;50(7):711-717. Free text link
CASO 131 (2da parte. H&E e inmunohistoquímica)
25 de octubre
Dra. Vanessa García Valencia / Dr. Reinhard Rodríguez Schotborgh Residentes de Dermatopatología Universidad CES. Dra. Camila Montoya. Profesora Universidad CES. Patóloga-Dermatopatóloga. MSPBS. Asunción, Paraguay.
Fotos clínicas cortesía Dr. Julián Cadavid, Dermatólogo Clínica Medellín. Medellín, Colombia.
Mujer 45 años. Pápula única, de superficie roja brillante en región púbica.
Con los hallazgos clínicos y microscópicos con tinción de H&E e inmunohistoquímica, ¿cuál es ahora el diagnóstico más apropiado?:
A. Hemangioma capilar lobular (granuloma piógeno)
B. Poroma ecrino
C. Nevus de Spitz
D. Melanoma amelanótico
E. Sarcoma de Kaposi
2da parte Inmunohistoquímica 1 de noviembre. Solución y cierre del caso 4 de noviembre
![]() F1 ASPECTO CLÍNICO DE LA LESIÓN | ![]() F2 | ![]() F3 |
|---|---|---|
![]() F4 | ![]() F5 | ![]() F6 |
![]() F7 | ![]() F8 | ![]() F9 VHH-8 / D2-40 |
![]() F10 WTI | ![]() F11 CD31 | ![]() F12 AML |
Respuestas
Sarcoma de Kaposi Adriana Balza Haddad
Sarcoma de Kaposi Carlos Cortés Caballero
Hemangioma capilar lobular Jacquelina Mugnier
Hemangioma capilar lobular Paula Difilippo
Hemangioma capilar lobular María del Mar Lorido
Hemangioma capilar lobular Andrés Fabián López
Sarcoma de Kaposi Lucy García Rodríguez
Hemangioma capilar lobular Ruth Mabel Vergara
Hemangioma capilar lobular Mary Escarabay
Hemangioma capilar lobular Elena Gallego Domínguez
Hemangioma capilar lobular Clara Jaramillo
Sarcoma de Kaposi Alberto Alvarado
Sarcoma de Kaposi Paola Prieto Pérez
Hemangioma capilar lobular Rolando Hernández Pérez
Sarcoma de Kaposi Francisco Javier Merino
Sarcoma de Kaposi Verónica Lizeth González Sánchez
Hemangioma capilar lobular Jaqueline Cifuentes Burbano
Hemangioma capilar lobular Paola Yolotzin Valenzuela Torres
Hemangioma capilar lobular Jaime Campuzano
Hemangioma capilar lobular Víctor León
Hemangioma capilar lobular Mayra Carrijo Rochael
Hemangioma capilar lobular Eduardo Garzón Aldas
Hemangioma capilar lobular Carlos Barria
Hemangioma capilar lobular Alvaro Ibarra Valencia
Respuestas 2da parte - H&E/IHQ
Hemangioma capilar lobular Ruth Mabel vergara
Melanoma amelanótico Indio Piícaro
Hemangioma capilar lobular María Gloria Mendoza de Sánchez
Hemangioma capilar lobular Guimar Jiménez
Hemangioma capilar lobular Fernando Cabo Gómez
Hemangioma capilar lobular Marjorie Cervantes
Hemangioma capilar lobular Mayra Carrijo Rochael
Hemangioma capilar lobular Gonzalo Eguiguren
Hemangioma capilar lobular Elizabeth Ball
Hemangioma capilar lobular Nelson Valdivia
Sarcoma de Kaposi Maria Isabel Moreno Vivanco
Hemangioma capilar lobular Andrés Favián
Hemangioma capilar lobular Enoi Vilar
Hemangioma capilar lobular Jesús Cuevas Santos
Hemangioma capilar lobular María del consuelo Gomer Y
Hemangioma capilar lobular Jaime Campuzano
Hemangioma capilar lobular Rita Mará Páez Trujillo
Hemangioma capilar lobular Mary Escarabay
Hemangioma capilar lobular Libia Jiménez
Poroma ecrino Thairine Lima
Hemangioma capilar lobular Enrique Bellolio
Hemangioma capilar lobular Lina Huérfano
Hemangioma capilar lobular Tania Garcés
Hemangioma capilar lobular Lizza Paz
Hemangioma capilar lobular Paola Yolotzin
Sarcoma de Kaposi Abril Trejo
Hemangioma capilar lobular Fernando Brenner
Respuesta
A. Hemangioma capilar lobular (granuloma piógeno) (correcta)
Descrito por primera vez en 1897 por Poncet y redefinido por Hartzell en 1904(1), corresponde a una lesión vascular reactiva adquirida, sin evidencia de naturaleza infecciosa. La etiopatogenia sigue siendo desconocida, sin embargo, parece estar asociado a una respuesta vascular excesiva que estimula la proliferación de vasos, secundario a un traumatismo previo, hipoxia o estrés oxidativo (3, 4). Puede surgir después de tratamientos depilatorios con láser, traumatismos, e inclusive dentro de malformaciones capilares. También se ha observado en relación con el embarazo y algunos medicamentos.
Se desarrolla con frecuencia en niños y adultos jóvenes, pero puede ocurrir a cualquier edad. Clínicamente se describe como una pápula eritematosa que crece rápidamente, de sangrado fácil y tendencia a la ulceración (F1) (2, 3). Generalmente ocurre en la piel y en las mucosas, pero se puede encontrar en cualquier localización del tracto gastrointestinal, respiratorio y genitourinario.
Histológicamente consiste una lesión polipoide cubierta por epitelio, en ocasiones con formación de collarete (F2-F4) y con una proliferación de vasos dispuestos en patrón multilobular, separados por delicados septos de tejido conectivo (F5,F6). Las células endoteliales y estromales son de apariencia reactiva, sin atipia citológica. Esta lesión suele coexistir con un infiltrado inflamatorio que varía en relación con el tiempo de la lesión y la presencia o no de erosión superficial. En etapas tempranas, se observa denso infiltrado mixto con polimorfonucleares, linfocitos y plasmocitos; mientras que en etapas tardías el infiltrado se hace escaso, representado por linfocitos, plasmocitos y mastocitos (F6-F8) (3,5). Los estudios de inmunohistoquímica confirman naturaleza vascular con positividad para CD31 (F10), y WT1 (F11), con AML positivo en el musculo liso vascular (F9) y negatividad para HHV8(F12).
B. Poroma ecrino: Aunque clínicamente puede presentar formación de collarete, los hallazgos histológicos hacen la distinción. Ver caso 21
C. Nevus de Spitz: La histología es muy diferente. Ver caso 66
D. Melanoma amelanótico: Clínicamente carece de pigmento, pudiendo confundir con otras lesiones. Sin embargo, el estudio histopatológico con H&E e inmunohistoquímica permite hacer la distinción fácilmente.
E. Sarcoma de Kaposi: En fase nodular pueden ser clínicamente parecidas. Sin embargo, la presencia de componente fusiforme atípico y la reactividad para HHV8 hacen la diferenciación. Ver caso 20
Referencias
-
Akamatsu T, Hanai U, Kobayashi M, Miyasaka M. Pyogenic Granuloma: A Retrospective 10-year Analysis of 82 Cases. Tokai J Exp Clin Med. 2015;40(3):110-114. Free Text Link
-
Rancan A, Boscarelli A, Codrich D, et al. Pyogenic granuloma arising within capillary malformations in children: A case report and literature review. Dermatol Reports. 2021;13(2):9115. Free Text Link
-
Banjar A, Abdrabuh A, Al-Habshi M, et al. Labial pyogenic granuloma related to trauma: A case report and mini-review. Dent Traumatol. 2020;36(4):446-45. Free Text Link
-
Motegi SI, Fujiwara C, Yamazaki S, et al. Possible contribution of autophagy in pyogenic granuloma. J Dermatol. 2018;45(9):1145-1146. Link
-
Hale CS. Capillary / pyogenic granuloma. PathologyOutlines.com website. Link
CASO 130
14 de septiembre
Dr. Javier Ricardo Hernandéz Moreno-Dr. Reinhard Rodríguez Schotborgh Residentes de Dermatopatología Universidad CES. Dra. Camila Montoya. Patóloga-Dermatopatóloga. MSPBS. Asunción, Paraguay. Dra. María Janeth Vargas. Médica Dermatopatóloga. Instituto Nacional de Cancerología. Bogotá. Profesora Programa de Dermatopatología Universidad CES. Medellín, Colombia.
Mujer, 74 años. Presenta pequeño nódulo asintomático y eritematovioláceo en el párpado inferior izquierdo, de 7 meses de evolución. Crecimiento lento. No antecedentes de importancia.
Con la información clínica y los hallazgos histopatológicos con HE y de inmunohistoquímica, ¿Cuál es el diagnóstico más apropiado?
A - Carcinoma mucinoso primario cutáneo
B - Carcinoma de glándulas sudoríparas endocrino productor de mucina
C - Carcinoma adenoide quístico
D - Carcinoma metastásico de mama
Histoquímica e inmunohistoquímica 30 de septiembre
Solución y cierre del caso 8 de octubre
![]() F1 | ![]() F2 | ![]() F3 |
|---|---|---|
![]() F4 | ![]() F5 | ![]() F6 |
![]() F7 Azul de Alcián | ![]() F8 CK7 | ![]() F9 R. Estrógenos |
![]() F 10 R. Progestágenos | ![]() F11 P63, EMA, Ki67 | ![]() F12 B Cromo, Sinaptof, NSE,CK20, CEA |
Respuestas
Carcinoma mucinoso primario cutáneo Sonia Tello
Ca de Gld Sud End productor de mucina Carlos Cortés Caballero
Ca de Gld Sud End productor de mucina Gerardo Prada Chona
Carcinoma mucinoso primario cutáneo Juan Manuel González Calle
Carcinoma mucinoso primario cutáneo Gustavo Antonio Posso García
Carcinoma mucinoso primario cutáneo Marcia Kibune
Carcinoma mucinoso primario cutáneo Mary Escarabay Ludeña
Ca de Gld Sud End productor de mucina Jaime Campuzano
Ca de Gld Sud End productor de mucina Gustavo Zanelli
Carcinoma mucinoso primario cutáneo Anónimo
Ca de Gld Sud End productor de mucina Adriana Balza Haddad
Ca de Gld Sud End productor de mucina Esther Mariela Estrada Martínez
Carcinoma mucinoso primario cutáneo Vanessa García Valencia
Carcinoma mucinoso primario cutáneo Camilo Andrés Pérez Montiel
Carcinoma mucinoso primario cutáneo Gonzalo Eguiguren Lira
Carcinoma mucinoso primario cutáneo Marioa Alexander Melo Uribe
Carcinoma mucinoso primario cutáneo Paola Yalotzin Valenzuela torres
Descartando primario originado en mamá o tracto intestinal por estudios auxiliares
Respuestas (Histoquímica e inmunohistoquímica)
Carcinoma mucinoso primario cutáneo Camilo Andrés Pérez Montiel
Ca de Gld Sud End productor de mucina Rolando Hernández Pérez
Carcinoma mucinoso primario cutáneo Anónimo
Carcinoma mucinoso primario cutáneo Lizbeth Andrea Ramírez
Carcinoma metastásico de mama Alberto Alvarado Erazo
Carcinoma mucinoso primario cutáneo Gonzalo Eguiguren
Carcinoma mucinoso primario cutáneo Isaira Torpoco
Carcinoma mucinoso primario cutáneo Lizza Paz
Carcinoma mucinoso primario cutáneo Karina Bravo
Carcinoma mucinoso primario cutáneo Elsa Bibiana Peña Zuñiga
Ca de Gld Sud End productor de mucina Jaime Campuzano
Carcinoma mucinoso primario cutáneo Pablo Espinosa Lara
Ca de Gld Sud End productor de mucina Anónimo
Carcinoma adenoide quístico Luz Mary Goez Herrera
Carcinoma metastásico de mama Francisco Javier Merino
Carcinoma metastásico de mama Jesús Cuevas
Carcinoma adenoide quístico Nancy Grandez
Carcinoma mucinoso primario cutáneo Vanessa García Valencia
Ca de Gld Sud End productor de mucina Ruth Mabel Vergara
Ca de Gld Sud End productor de mucina Esther Mariela Estrada martínez
Carcinoma mucinoso primario cutáneo Juan Manuel González Calle
Carcinoma metastásico de mama Raquel Barrón
Carcinoma mucinoso primario cutáneo Omar Alexis Gómez Rodríguez
Carcinoma mucinoso primario cutáneo Luz Mary Goez Herrera
Carcinoma mucinoso primario cutáneo Santiago López
Respuesta
A. Carcinoma mucinoso primario cutáneo (correcta)
Descrito por primera vez por Lennox et al en 1952, es una neoplasia poco frecuente derivada al parecer del epitelio glandular conjuntival. Aparece con mayor frecuencia en cabeza y cuello de pacientes ancianos(1), principalmente en los párpados, aunque se han descrito en otras localizaciones como el abdomen(2), manos y vulva. Clínicamente, se manifiesta como un nódulo indurado o ulcerado de color rojizo o azulado, sin ningún hallazgo en particular que permita su diagnóstico.
Histológicamente, se caracteriza por la presencia de lagos de mucina separados por delgados septos fibrosos (F1, 2, 5), entre los lagos se reconoce la presencia de células tumorales cuboidales de núcleo ovalado central (F3), pueden encontrarse áreas de diferenciación glandular, sólida, micropapilar (F4) o cribiforme (F5, F6)(3).
Los depósitos de mucina son positivos con la coloración de alcian blue (F7), asimismo son PAS positivos resistentes a la diastasa. En los estudios de inmunohistoquímica, las células tumorales muestran positividad para CK7 (F8), CAM 5.2, receptores de estrógenos (F9), receptores de progesterona (F10), EMA (F11) y CEA (F12) y negatividad para CK20 (F12). Se han descrito algunos casos con diferenciación neuroendocrina que expresan los marcadores cromogranina, sinaptofisina y enolasa neuronal específica, los cuales fueron negativos en nuestro caso (F12). Se pueden reconocer áreas de carcinoma in situ por la presencia de células mioepiteliales evidentes con p63 (F11) o AML.
Los diagnósticos diferenciales incluyen otros tumores productores de mucina. Es por ello que, durante la evaluación de estos pacientes, se debe realizar un examen físico riguroso con énfasis en los antecedentes y evaluación de otros estudios de extensión.
B. Carcinoma de glándulas sudoríparas endocrino productor de mucina (incorrecta)
Es similar al carcinoma sólido papilar de mama y puede estar asociado al carcinoma mucinoso invasor con presencia de áreas sólidas, quísticas, papilares y cribiformes, la producción de mucina es variable y puede estar presente de forma extracelular e intracelular. Expresan los marcadores cromogranina, sinaptofisina, enolasa neuronal específica (negativos en nuestro caso (F12)), EMA y CK7 con positividad intensa de INSM1 y MUC2(4) (no realizados en este caso). La tendencia actual es considerar este tumor como una variante de mejor pronóstico que el carcinoma mucinoso primario cutáneo.
C. Carcinoma adenoide quístico (incorrecto)
Aparece con mayor frecuencia en las glándulas salivales, con 3 patrones histológicos: tubular, cribiforme y sólido, siendo el primero el más frecuente. Ocasionalmente pueden tener producción focal de mucina(5). La localización y el patrón citoarquitectural son diferentes a la lesión presentada en este caso.
D. Carcinoma metastásico de mama (incorrecto)
Aunque la morfología y el perfil de inmunohistoquímica del caso presentado es muy similar al del carcinoma de mama, esta paciente no tenía antecedentes, asimismo, al examen físico y en los estudios de extensión, se descartó su presencia.
Bibliografía
-
Javaid, Hussnain, et al. Unusual skin mass (primary cutaneous mucinous carcinoma). Case Reports. 2018 (2018): bcr-2017. Free Text Link
-
Miyata, Kazunori, et al. Primary Cutaneous Mucinous Carcinoma of the Abdomen. Annals of Dermatology 31.3 (2019): 339. Free Text Link
-
Tak, Min Sung et al. Primary Cutaneous Mucinous Carcinoma of the Eyelid. Archives of craniofacial surgery vol. 17,3 (2016): 176-179. Free Text Link
-
Quattrochi, Brian, and Eleanor Russell-Goldman. Utility of Insulinoma-Associated Protein 1 (INSM1) and Mucin 2 (MUC2) Immunohistochemistry in the Distinction of Endocrine Mucin-Producing Sweat Gland Carcinoma From Morphologic Mimics. The American Journal of dermatopathology. PubMed
-
Coca-Pelaz, Andrés et al. Adenoid cystic carcinoma of the head and neck--An update. Oral oncology vol. 51,7 (2015): 652-61. PubMed
CASO 129
1 de septiembre
Dra. Vanessa García Valencia - Dr. Reinhard Rodríguez Schotborgh Residentes de Dermatopatología Universidad CES. Dra. Camila Montoya. Patóloga-Dermatopatóloga. MSPBS. Asunción, Paraguay. Dr. Rodrigo Restrepo. Profesor Programa Dermatopatología Universidad CES. Dr Rodrigo Restrepo profesor Programa Dermatopatología Universidad CES. Medellín. Col
Fotos clínicas cortesía Dr. Ernesto Peña Santamaría Dermatólogo Clínica Medellín. Medellín, Colombia.
Paciente femenina de 49 años. Lesión nodular en pabellón auricular. Con los hallazgos clínicos y microscópicos, ¿Cuál es el diagnóstico más apropiado?:
A. Queratoacantoma
B. Pseudoquiste auricular
C. Condrodermatitis nodular
D. Condroma auricular
Solución y cierre del caso 9 de septiembre
![]() F1 | ![]() F2 | ![]() F3 |
|---|---|---|
![]() F4 | ![]() F5 | ![]() F6 |
![]() F7 | ![]() F8 | ![]() F9 |
Respuestas
Condrodermatitis nodular María Janet Vargas M.
Queratoacantoma Bertha Julieth Garzón Mora
Condrodermatitis nodular Camilo Andrés Pérez Montiel
Queratoacantoma Carlos Cortés Caballero
Condrodermatitis nodular Jesús Cuevas Santos
Condrodermatitis nodular Nelson Valdivia Díaz
Condrodermatitis nodular Marcia Kibune
Condrodermatitis nodular Jackeline Mugnier
Queratoacantoma Alfonso Rubio
Condrodermatitis nodular Víctor Otero
Queratoacantoma Nancy Grandez
Queratoacantoma Ligia Méndez
Condrodermatitis nodular Griselda de Anda
Condrodermatitis nodular Sonia Tello
Condrodermatitis nodular Gustavo Posso García
Pseudoquiste auricular Anónimo
Condrodermatitis nodular Alejandra Toro
Condrodermatitis nodular Esther Mariela Estrada Martínez
Condrodermatitis nodular Juan Manuel González Calle
Condrodermatitis nodular Alberto Alvarado Erazo
Condrodermatitis nodular Gonzalo Eguiguren Lira
Queratoacantoma Rolando Hernández Pérez
Condrodermatitis nodular María Gloria Mendoza de Sánchez
Condrodermatitis nodular Regina Barros Domíngues
Condrodermatitis nodular Marco Alfonso Nieto García
Condrodermatitis nodular Mayra Carrijo-Rochael
Condrodermatitis nodular Luz Mary Goez Herrera
Condrodermatitis nodular Jaime Campuzano
Condrodermatitis nodular Carmen Camauta
Queratoacantoma Anónimo
Respuesta
C. Condrodermatitis nodular.
La condrodermatitis nodular del hélix (CNH) es una entidad inflamatoria benigna descrita por Winkler en 1915(1), agrupada dentro de las dermatosis con eliminación transepidérmica. Suele afectar el hélix de hombres entre la cuarta y sexta década de la vida, aunque en mujeres es muy característico el compromiso del antihélix (F1)(2). Clínicamente se describe como un nódulo pequeño solitario, de color pardo-violáceo, asociado a ulceración central (F1-F2)(1,2). Se considera excepcional el compromiso bilateral y en pacientes jóvenes(3).
La fisiopatología es multifactorial, siendo el trauma crónico del pabellón auricular (presión de la almohada, uso de auriculares de diadema) el factor más importante. Se han relacionado otros factores como el daño solar, alteraciones en la irrigación arterial y cambios degenerativos del cartílago. Todos estos cambios confluyen en fenómenos isquémicos transitorios que producen daño de las fibras colágenas de la dermis con necrosis fibrinoide y estimulan el proceso de eliminación transepidérmica (4).
Las características histológicas de la CNH dependen de la fase evolutiva de la lesión, presentando en etapas tempranas cambios muy inespecíficos con depósito de fibrina subepidérmica y cambios epidérmicos reactivos. En etapas finales se reconoce una lesión en cráter(F3) con un centro ulcerado que contiene abundante material fibrinoide eosinofílico que protruye hacia el exterior (F4,F5)(3,5). La base de la lesión presenta proliferación capilar y tejido de granulación, con trombosis, extravasación eritrocitaria e infiltrado linfohistiocitario variable(F7,F9). Adyacente a la úlcera, la epidermis muestra marcada acantosis y paraqueratosis(F6), con cambios reactivos sin atipia, además del acúmulo de fibrina subepitelial dscrito (F8)(5). Generalmente no se reconoce daño del cartílago auricular. El diagnóstico es sencillo con una adecuada correlación clínico-patológica, siendo necesario esta última para descartar los diagnósticos diferenciales.
A. Queratoacantoma: La evaluación histológica permite distinguir esta entidad de la CNH. En este caso, no se reconoce proliferación escamosa ni tapón de queratina compacta. Ver Caso 80.
B. Pseudoquiste auricular: El compromiso del pseudoquiste auricular es del cartílago auricular, sin inflamación o ulceración. Ver Caso 125.
D. Condroma auricular: Corresponde a una neoplasia mesenquimal benigna formadora de cartílago, rara vez presenta inflamación o ulceración.
Bibliografía
-
Winkler M. Knötchenförmige Erkrankung am Helix. Archiv für Dermatologie und Syphilis. 1915;121(2):278-285. Free Text Link
-
Kaur R, Lee A, Feldman S. Bilateral chondrodermatitis nodularis chronica helicis on the antihelix in an elderly woman. International Journal of Dermatology. 2010;49(4):472-474. Free Text Link
-
Lehmer L, Roseman V, Lundquist K. Chondrodermatitis nodularis helicis in an adolescent boy: not just for old men. Cutis. 2019;104(5):E6-E8. Free Text Link
-
Magro C, Frambach G, Crowson A. Chondrodermatitis nodularis helicis as a marker of internal syndromes associated with microvascular injury. Journal of Cutaneous Pathology. 2005;32(5):329-333. Free Text Link
-
Vázquez‐López F, Gómez‐Vila B, Vázquez‐Losada B, et al. Chondrodermatitis nodularis helicis in the 21st century: demographic trends from a gender and age perspective. A single University hospital retrospective histopathological register study of 215 patients in Asturias, North Spain (2000–2017). Journal of the European Academy of Dermatology and Venereology. 2021;35(8). Free Text Link
CASO 128
17 de agosto
Dr. Juan Eduardo Rocha Aguirre - Dr. Reinhard Rodríguez Schotborgh Residentes de Dermatopatología Universidad CES. Dra. Camila Montoya. Patóloga-Dermatopatóloga. MSPBS. Asunción, Paraguay. Dr Andrés Flórez Jefe Programa Dermatopatología Universidad CES.
Fotos clínicas cortesía Dra. Carolina Velásquez Botero Docente Programa Dermatología Universidad CES, Medellín, Colombia.
Hombre, 39 años. Lesión nodular en espalda. Con los hallazgos clínicos y microscópicos, ¿cuál es el diagnóstico más apropiado?:
A. Linfangioma circunscrito
B. Sarcoma de Kaposi
C. Hemangioma targetoide hemosiderotico
D. Hemangioma microvenular
Solución y cierre del caso 29 de agosto
![]() F1 | ![]() F2 | ![]() F3 |
|---|---|---|
![]() F4 | ![]() F5 | ![]() F6 |
![]() F7 | ![]() F8CD31 | ![]() F9WT1 |
![]() F10D2-40 / HHV8 |
Respuestas
H. targetoide hemosiderótico Elizabeth Milena Arciniegas
Linfangioma circuncrito María Salomé Ramírez
H. targetoide hemosiderótico Diana Palacios Narváez
Hemangioma microvenular Alberto Alvarado Erazo
Hemangioma microvenular Beatriz Di Martino
Hemangioma microvenular Pablo Espinosa Lara
H. targetoide hemosiderótico Astrid Lorena Ruiz Rodríguez
Hemangioma microvenular Lizza Paz
Hemangioma microvenular Víctor Manuel Delgado
Hemangioma microvenular Carlos Cortés Caballero
Hemangioma microvenular Erendira Cervantes
Sarcoma de Kaposi Mónica Gaviria
Hemangioma microvenular Mayra Carrijo-Rochael
Hemangioma microvenular Gerardo Enrique Prada
Hemangioma microvenular Valeria Ureña
Hemangioma microvenular Camilo Andrés Pérez Montiel
H. targetoide hemosiderótico Regina Barros Domingues
Hemangioma microvenular Luis Moreno
H. targetoide hemosiderótico Juan David Ruiz
Hemangioma microvenular Marco Alfonso Nieto García
Hemangioma microvenular Jesus Cuevas Santos
Hemangioma microvenular Fernando Cabo Gómez
Hemangioma microvenular Elena Gallego Domínguez
Hemangioma microvenular Jaime Campuzano
Sarcoma de Kaposi Lucy García Rodríguez
Sarcoma de Kaposi Luisa Montilla
Hemangioma microvenular Esther Mariela Estrada Martínez
Hemangioma microvenular Gustavo Antonio Posso García
Hemangioma microvenular Milena del Pilar Barrera Sandoval
Hemangioma microvenular María Gloria Mendoza de Sánchez
Hemangioma microvenular Carmen Camauta
Hemangioma microvenular María del Mar Lorido
Hemangioma microvenular Carlos Barria
Respuesta
D. Hemangioma microvenular (HM)
Se trata de una neoplasia vascular benigna infrecuente, descrita inicialmente por Hunt en 1991 (1). Esta lesión se presenta en adultos jóvenes, con un ligero predominio en el sexo femenino. Aunque su etiología sigue siendo desconocida, se han reportado asociaciones con inmunosupresión, embarazo y uso de anticonceptivos (2). Clínicamente se describe como una placa única asintomática eritematoviolácea, de bordes definidos y tamaño entre 0.5 a 2 cm, localizada en tronco y extremidades (F1) (3).
Microscópicamente, se observa proliferación no circunscrita de vasos sanguíneos de pared delgada, tapizados por endotelio sin atipias y ramificados. Estos vasos se distribuyen en la dermis reticular superficial y profunda (F2-F4) con un patrón infiltrativo entre las fibras de colágeno (F5) e invasión a los anexos cutáneos, siendo muy típica la infiltración al músculo piloerector (F6-F7) (2). Se han descrito casos excepcionales que presentan infiltrado linfoplasmocitario, endotelio con aspecto “en tachuela” y focal extravasación de eritrocitos (3,4). Mediante inmunohistoquímica se observa positividad para marcadores endoteliales como CD31 (F8), CD34, ERG y WT1 (F9); con negatividad para HHV8, D2-40 (F10) y GLUT1 (5).
A. Linfagioma circunscrito: Se distingue del HM por la distribución en dermis papilar, la ausencia de eritrocitos y positividad para D2-40.
B. Sarcoma de Kaposi (SK): Suele ser el diagnóstico diferencial más preocupante, por la similitud entre el SK en fase temprana y el HM. Aunque ambas entidades pueden presentar extravasación de eritrocitos e infiltrado linfoplasmocitario, estas características son mucho más frecuentes en el SK. Además, el SK presenta un patrón infiltrativo más complejo, con canales vasculares anastomosantes y presencia del signo del promontorio. La inmunohistoquímica con HHV8 resulta ser la mejor herramienta para su diagnóstico. Ver caso 20.
C. Hemangioma targetoide hemosiderótico: Se distingue del HM por la presencia de hemosiderina y células endoteliales con aspecto en tachuela predominantes. Por inmunohistoquímica presenta positividad para D2-40, demostrando su linaje linfático. Ver caso 79.
Bibliografía:
1. Trindade F, Kutzner H, Requena L, et al. Microvenular Hemangioma—An Immunohistochemical Study of 9 Cases. The American Journal of Dermatopathology. 2012;34(8):810-812. PubMed
2. Juan Y, Chen C, Hsiao C, Chiu T. A microvenular hemangioma with a rare expression of progesterone receptor immunocreativity and a review of the literature. Journal of Cutaneous Pathology. 2018;45(11):847-850. Free text link
3. Napekoski K, Fernandez A, Billings S. Microvenular hemangioma: a clinicopathologic review of 13 cases. Journal of Cutaneous Pathology.
2014;41(11):816-822. Free text link
4. Tur-González R, González-de Arriba A, Martín-López M, Ramos-Nieto M. Hemangioma microvenular: lesión vascular benigna de patrón infiltrante. Presentación de 3 casos y revisión de la literatura. Revista Española de Patología. 2015;48(4):203-207. Pubmed
5. van Vugt L, van der Vleuten C, Flucke U, Blokx W. The utility of GLUT1 as a diagnostic marker in cutaneous vascular anomalies: A review of literature and recommendations for daily practice. Pathology - Research and Practice. 2017;213(6):591-597. Pubmed
CASO 127
22 de julio
Drs. Vanessa García Valencia - Reinhard Rodríguez S. Residentes de dermatopatología Universidad CES. Dra. Camila Montoya. Patóloga-Dermatopatóloga. MSPBS. Asunción, Paraguay. Dr. Andrés Flórez Posada. Dermatopatólogo coordinador del programa de dermatopatología Universidad CES.
Fotos clínicas cortesía Dr. Julían Cadavid Peña. Dermatólogo Universidad CES, Medellín, Colombia.
Paciente femenino de 37 años. Lesión nodular en pliegue interglúteo.
Con los hallazgos clínicos y microscópicos, ¿cuál es el diagnóstico más apropiado?:
A. Poroqueratosis ptychotropica
B. Hidradenoma papilliferum
C. Siringocistoadenoma papiliferum
D. Hidradenoma nodular con componente papilar
Solución y cierre del caso 9 de agosto
![]() F1 | ![]() F2 | ![]() F3 |
|---|---|---|
![]() F4 | ![]() F5 | ![]() F6 |
![]() F7 |
Respuestas
Hidradenoma papilliferum Idania Lubo
Hidradenoma papilliferum Sonia Tello
Siringocistadenoma papilliferum Liza Paz
Hidradenoma papilliferum Juan Manuel González
Hidradenoma papilliferum Mayra Carrijo Rochael
Hidradenoma nodular (papilar) Karol Baksai
Hidradenoma papilliferum Guimar Jiménez
Hidradenoma nodular (papilar) Jaime Campuzano
Hidradenoma papilliferum Astrid Lorena Ruiz
Siringocistadenomaa papilliferum Martha Isabel Mora
Hidradenoma papilliferum Lili Rueda
Hidradenoma papilliferum Estela Albor
Siringocistadenomaa papilliferum Mafe Tibaduiza
Hidradenoma papilliferum Carolina Giraldo
Hidradenoma papilliferum Guillermo Ramos Rodríguez
Siringocistadenomaa papilliferum Adriana Balza Haddad
Hidradenoma papilliferum Mónica Gaviria
Hidradenoma papilliferum María Janeth Vargas
Siringocistadenomaa papilliferum Elena Gallego Domínguez
Hidradenoma papilliferum Luciana Battipiede
Hidradenoma papilliferum Karina Bravo
Hidradenoma papilliferum Libis Jiménez
Hidradenoma papilliferum Milton Mejía
Hidradenoma papilliferum Rolando Hernández Pérez
El hidradenoma papilífero es una variante del adenoma apocrino
Siringocistadenomaa papilliferum Víctor Manuel Delgado
Hidradenoma papilliferum Esther Mariela Estrada M.
Hidradenoma papilliferum Carmen Camauta
Hidradenoma nodular (papilar) Carlos Cortés Caballero
Hidradenoma papilliferum Clara Jaramillo
Siringocistadenomaa papilliferum Valeria Ureña
Respuesta
B. Hidradenoma papilífero
Neoplasia benigna descrita por primera vez por Werth en 1878, originada de glándulas apocrinas y anogenitales similares a las glándulas mamarias (1,2). Clínicamente se describe como una pápula o nódulo solitario de color pardo rojizo (F1), casi exclusivo de mujeres (2). Sin embargo, existen algunos reportes aislados de hidradenoma papilífero perianal en pacientes masculinos (3).
Su origen histológico se encuentra compartido con otras entidades como el adenoma tubular apocrino, el siringocistadenoma papilliferum y el adenoma papilar ecrino. De ahí el solapamiento morfológico e inmunofenotípico que suelen tener todas estas neoplasias (2,4).
Al estudio histológico se aprecia una lesión quística compuesta por células cúbicas o columnares internas que muestran secreción de apocrina, delimitadas por células mioepiteliales. Esta neoplasia se dispone en frondas, túbulos y papilas (F3-F7), los cuales se extienden hacia la dermis profunda frecuentemente sin conexión con la epidermis (F2) (2,4). Los estudios de inmunohistoquímica suelen reflejar el origen glandular con características similares a las glándulas mamarias (2,5). Las células tumorales generalmente son positivas para receptores de estrógeno y progesterona, además de receptores de andrógenos. Además, la lesión presenta una hilera de células mioepiteliales bien definida que se resalta con marcadores como p63, actina de músculo liso, entre otros (2).
A. Poroqueratosis ptychotropica: Esta entidad se caracteriza por presentar cambios predominantemente epidérmicos como paraqueratosis columnar formando lamelas coronoides e hipogranulosis, los cuales se encuentran ausentes en este caso.
C. Siringocistoadenoma papilliferum (SCAP): Aunque en esencia se pueden considerarse como parte de una misma familia de tumores, el SCAP presenta características morfológicas distintivas. Este tumor generalmente presenta conexión epidérmica, infiltrado linfoplasmocitario en el estroma periglandular y ausencia de componente mioepitelial acompañante en las estructuras papilares.
D. Hidradenoma nodular con componente papilar: Aunque resultan tener nombres similares, los hidradenomas nodulares corresponden a neoplasias de origen ecrino, las cuales se caracterizan por presentar un patrón predominantemente sólido, con presencia de múltiples poblaciones celulares (cuticulares, poroides, células claras), las cuales presentan frecuentemente diferenciación ductal.
Bibliografía:
-
Seo GJ, Seo JH, Cho KJ, Cho HS. Hidradenoma Papilliferum of the Anus: A Report of 2 Cases and Review of the Literature. Ann Coloproctol. 2019;35(6):361-363. Free text Link
-
Konstantinova, Anastasia M et al. “Hidradenoma Papilliferum: A Clinicopathologic Study of 264 Tumors From 261 Patients, With Emphasis on Mammary-Type Alterations.” The American Journal of dermatopathology vol. 38,8 (2016): 598-607. Free text Link:
-
Kondo RN, Melhado IP, Moreira CR, Crespigio J. Ectopic hidradenoma papilliferum. An Bras Dermatol. 2018;93(3):474-475. Free text Link
-
Parks, Ashley et al. “Hidradenoma papilliferum with mixed histopathologic features of syringocystadenoma papilliferum and anogenital mammary-like glands: report of a case and review of the literature” The American Journal of dermatopathology vol. 34,1 (2012): 104-9. Pubmed
-
Patel S, Lambert WC, Behbanani S, Espinal-Mariotte JD, Lee P. Hidradenoma Papilliferum: Everyone Else's Diagnosis. Indian J Dermatol. 2020;65(2):151-153. Free text
CASO 126
5 de julio
Drs. Vanessa García Valencia - Juan Eduardo Rocha Aguirre. Residentes de dermatopatología Universidad CES. Dra. María del Mar Serna Posada. Residente de dermatología Universidad CES. Dra. Camila Montoya. Patóloga-Dermatopatóloga. MSPBS. Asunción, Paraguay.
Dr. Andrés Flórez Posada. Dermatopatólogo coordinador del programa de dermatopatología Universidad CES.
Fotos clínicas cortesía Dra. Paula Mejía Zapata. Dermatóloga UPB. Medellín, Colombia.
Hombre de 35 años con pápulas violáceas asintomáticas en dorso de la mano de varios años de evolución.
¿Con la imagen clínica, histología y el perfil inmunohistoquímico, cuál es el diagnóstico más probable?
A- Verruga vulgar
B- Hamartoma angiomatoide ecrino
C- Eritema elevatun diutinum
D- Nevus ostial ecrino
Solución y cierre del caso 12 de julio
![]() F1 | ![]() F2 | ![]() F3 |
|---|---|---|
![]() F4 | ![]() F5 | ![]() F6 |
![]() F7 | ![]() F8CK 5 - 6 | ![]() F9CD 31 |
![]() F10EMA | ![]() F11SOX10 |
Respuestas
Hamartoma angiomatoide ecrino Edwin Enrique Vega Munive
Hamartoma angiomatoide ecrino Laura Jaramillo
Hamartoma angiomatoide ecrino Anónimo
Nevus ostial ecrino Astrid Lorena Ruiz Rodríguez
Hamartoma angiomatoide ecrino Juan Manuel González
Hamartoma angiomatoide ecrino Erika blancas
Hamartoma angiomatoide ecrino Carolina Cabrera Salom
Hamartoma angiomatoide ecrino María Janeth Vargas
Nevus ostial ecrino Melissa Quintero
Verruga Vulgar Esther Mariela Estrada
Hamartoma angiomatoide ecrino Güímar Jiménez
Hamartoma angiomatoide ecrino Elizabeth Milena Arciniegas
Hamartoma angiomatoide ecrino Beatriz di Martino
Hamartoma angiomatoide ecrino Mónica Ruiz Ballón
Hamartoma angiomatoide ecrino Jaime Campuzano
Hamartoma angiomatoide ecrino Jesús Cuevas Santos
Hamartoma angiomatoide ecrino María del Mar Lugo
Hamartoma angiomatoide ecrino Fernando cabo Gómez
Hamartoma angiomatoide ecrino Carmen Camauta
Eritema elevatun diutinum Linda Chaustre
Hamartoma angiomatoide ecrino Carmen López
Hamartoma angiomatoide ecrino Lili Rueda
Hamartoma angiomatoide ecrino Sabrina Viviana Herrera
Nevus ostial ecrino Lucy García Rodríguez
Hamartoma angiomatoide ecrino Sonia Tello
Hamartoma angiomatoide ecrino Mayra Rochael
Hamartoma angiomatoide ecrino Paula Difilippo
Hamartoma angiomatoide ecrino José Manuel García Rodríguez
Hamartoma angiomatoide ecrino Marcia Kibune
Hamartoma angiomatoide ecrino Rolando Hernández Pérez
Hamartoma angiomatoide ecrino Nancy Grandez
Hamartoma angiomatoide ecrino Paola Prieto Pérez
Hamartoma angiomatoide ecrino Liliana Aristizábal
Hamartoma angiomatoide ecrino Víctor Leóm
Hamartoma angiomatoide ecrino Karol Baksai Elespuru
Hamartoma angiomatoide ecrino Gonzalo Eguiguren
Hamartoma angiomatoide ecrino María del Consuelo Gómez Y
Hamartoma angiomatoide ecrino Rita María Páez Trujillo
Hamartoma angiomatoide ecrino Alberto Alvarado Erazo
Hamartoma angiomatoide ecrino Elena Gallego Domínguez
Hamartoma angiomatoide ecrino Libia Jiménez Jiménez
Respuesta
B. Hamartoma angiomatoide ecrino
Descrito por primera vez en 1859 como una lesión de apariencia angiomatosa (1,2). No tiene distinción de género y se presenta al nacer o en la primera infancia como un placa o nódulo rojo violáceo, marrón azuloso o amarillo de localización predominantemente en extremidades. Se han reportado algunos casos de lesiones múltiples en otros sitios anatómicos (2,3). Su etiología aún no se ha esclarecido, sin embargo, se ha planteado la hipótesis de un fallo epitelial y mesenquimal, que genera una proliferación anormal de estructuras anexiales ecrinas y vasculares. Parece ser que la presentación en adultos puede estar relacionada con traumas repetitivos (3,4). Clínicamente se observan nódulos, pápulas o placas predominantemente solitarias o múltiples (4). La mayoría son asintomáticos. Ocasionalmente el compromiso de estructuras nerviosas puede ocasionar dolor, aumento local de la temperatura o hiperhidrosis (3).
El diagnóstico se confirma con el estudio histopatológico donde se observa una lesión hamartomatosa localizada en la dermis media o reticular, caracterizada por proliferación de estructuras ecrinas bien diferenciadas, estrechamente asociadas con aumento de canales vasculares de paredes delgadas con apariencia dilatada que se disponen en lóbulos (1,3,5).
Con los estudios de inmunohistoquímica se observa positividad para CD31 en el componente vascular y el componente ecrino exhibe reactividad para SOX10 en patrón nuclear, CK5-6 a nivel del epitelio y con EMA positivo en los ductos.
Se han identificado variantes histopatológicas inusuales que incluyen la infiltración de tejido adiposo, la presencia de estructuras pilares, glándulas apocrinas o incluso incremento de mucina dérmica subyacente (5).
A. Verruga vulgar: No se observan los hallazgos epidérmicos característicos con hiperqueratosis, papilomatosis y coilocitos.
C. Eritema elevatun diutunum: No se observa vasculitis leucocitoclástica, fibrosis concéntrica ni estoriforme ni áreas de xantomizadas.
D. Nevus ostial ecrino: Esta entidad se caracteriza por la invaginación epidérmica ocupada por una columna de paraqueratosis con pérdida de la capa granulosa que surge en la abertura de un ducto ecrino.
BIBLIOGRAFÍA
-
Martinelli PT, Tschen JA. Eccrine angiomatous hamartoma: a case report and review of the literature. Cutis. 2003 Jun;71(6):449-55. PubMed
-
Hyman AB, Harris H, Brownstein MH. Eccrine angiomatous hamartoma. N Y State J Med. 1968 Nov 1;68(21):2803-6. PubMed
-
Sanusi T, Li Y, Sun L, Wang C, Zhou Y, Huang C. Eccrine Angiomatous Hamartoma: A Clinicopathological Study of 26 Cases. Dermatology. 2015;231(1):63-9. PubMed
-
Morrell DS, Ghali FE, Stahr BJ, McCauliffe DP. Eccrine angiomatous hamartoma: a report of symmetric and painful lesions of the wrists. Pediatr Dermatol. 2001 Mar-Apr;18(2):117-9. PubMed
-
Batalla A, Rosón E, Flórez A, Troncoso A, de la Torre C. Hamartoma angiomatoso ecrino: presentación de dos casos. Actas Dermosifiliogr. 2011;102(4):289-292. Free Text Link
CASO 125
8 de junio
Drs. Juan Rocha / Reinhard Rodríguez. Residentes de dermatopatología universidad CES. Medellín, Colombia. Dra. Camila Montoya. Patóloga-Dermatopatóloga. MSPBS. Asunción, Paraguay.
Fotos clínicas cortesía Dra. Sandra Vélez Ortiz. Dermatóloga Universidad de Antioquia, Dermatóloga Salud Sura. Medellín, Colombia.
Hombre caucásico de 43 años, con lesiones nodulares en hélix derecho de 3 meses de evolución. Son de consistencia cauchosa, confluyentes, de crecimiento lento y asintomáticas. Sin antecedente de trauma
¿Con la imágenes suministradas, cuál es el diagnóstico más probable?
A- Condrodermatitis nodular
B- Nódulo elastótico
C- Pseudoquiste auricular
D- Amiloidosis
Solución y cierre del caso 21 de junio
Respuestas
Pseudoquiste auricular Mónica Gaviria
Condrodermatitis nodular Beatriz di Martino
Pseudoquiste auricular Guimar Jiménez
Condrodermatitis nodular Liza Paz
Condrodermatitis nodular Regina Barros Domíngues
Pseudoquiste auricular María Janeth Vargas
Condrodermatitis nodular Jennifer Correa Rodríguez
Pseudoquiste auricular Alberto Alvarado Erazo
Pseudoquiste auricular Esther Mariela Estrada
Condrodermatitis nodular Lina Huérfano
Pseudoquiste auricular Vanessa García Valencia
Condrodermatitis nodular Abril Trejo Caballero
Amiloidosis Edwin Enrique Vega
Amiloidosis María Isabel Moreno Vivanco
Pseudoquiste auricular Fernando Cabo Gómez
Pseudoquiste auricular Verónica Posso
Pseudoquiste auricular Elena Gallego Domínguez
Condrodermatitis nodular Jaime Soto
Pseudoquiste auricular Armando Muñoz
Pseudoquiste auricular Eduardo Garzón Aldas
Pseudoquiste auricular Carlos Cortes Caballero
Pseudoquiste auricular María Gloria Mendoza
Pseudoquiste auricular Julia Mesa
Condrodermatitis nodular Jaime Campuzano
Pseudoquiste auricular Yolima Mercado
Pseudoquiste auricular Libia Jiménez
Condrodermatitis nodular Alicia Benavides
Pseudoquiste auricular Libia Jiménez Jiménez
Condrodermatitis nodular Paola Prieto Pérez
Condrodermatitis nodular María mercedes Torres Sanz
Pseudoquiste auricular Lourdes Díaz
Pseudoquiste auricular Elena Voica
Condrodermatitis nodular Ligia Méndez
Pseudoquiste auricular Mónica Zapata
Respuesta
C. PSEUDOQUISTE AURICULAR (PA)
También denominado condromalacia quística idiopática, corresponde a una lesión benigna descrita por Hartmann (F9) en 1846, consistente en un proceso poco frecuente de cambio quístico del cartílago auricular (1). Se presenta con mayor frecuencia en hombres entre la tercera y quinta década, con predominio en pacientes caucásicos o asiáticos (2). La etiología del PA sigue siendo desconocida (3).
Se trata de un engrosamiento no doloroso a nivel de la concha auricular (F1). Suele ser unilateral (F2) y comprometer la porción superior de la concha, usualmente en la fosa escafoides o triangular (3).
Histológicamente, se observa una cavitación dentro del cartílago sin revestimiento epitelial (F4, F5). El interior de la cavidad suele contener material seroso (F5) aunque se han descrito casos con contenido hemático. La epidermis y la dermis superficial no presentan alteraciones (F3) (3,4). Se ha intentado (sin éxito) caracterizar el contenido de la lesión con tinciones especiales. En este caso, la tinción con azul alcian revela acumulación de polisacáridos ácidos y mucina dentro del cartílago, siendo negativo en el material dentro de la cavidad (F6-F8) (5).
A. Condrodermatitis nodular (CN): Por su localización e incidencia suele confundirse con el PA. Sin embargo, clínica e histológicamente son fáciles de distinguir. La CN pertenece al grupo de las dermatosis perforantes, siendo una lesión dolorosa a nivel del hélix asociada a trauma repetitivo. Los hallazgos histológicos corresponden a una epidermis usualmente ulcerada con depósitos de fibrina en la dermis papilar y proliferación capilar, acompañado del proceso de eliminación de fibras de colágeno. El daño del cartílago se considera un fenómeno raro.
B- Nódulo elastótico: Consiste en una marcada degeneración elastótica de la dermis formando una lesión nodular en dermis, sin comprometerse el cartílago auricular.
D- Amiloidosis: De las tantas formas de amiloidosis cutánea, la forma nodular es quizá la más parecida clínicamente. Sin embargo, suelen distinguirse del PA con relativa facilidad. En la forma nodular se observa colección de material amorfo débilmente eosinofílico dentro de la dermis. Este material se suele identificar con tinciones como rojo Congo o cristal violeta. El cartílago auricular no se observa alterado.
BIBLIOGRAFÍA
-
Hartmann A. Uber cystenbildung in der ohrenmuschel. Arch Ohren Nasen Kehlkopfheilkd. 1846;15:156-66
-
Ramadass T, Ayyaswamy G. Pseudocyst of auricle - etiopathogenesis, treatment update and literature review. Indian J Otolaryngol Head Neck Surg. 2006;58:156-159. Free Text Link
-
Cader SHA, Shah FA, Reghunandanan Nair SKG. Clinico-pathological profile and comparative study of conservative versus surgical deroofing as an effective technique in management of pseudocyst of pinna. World J Otorhinolaryngol Head Neck Surg. 2018;4:234-239. Free Text Link
-
Lim CM, Goh YH, Chao SS, Pseudocyst of the auricle: a histologic perspective. Laryngoscope. 2004 Jul;114:1281-4. Pubmed
-
Lee JA, Panarese A. Endochondral pseudocyst of the auricle. J Clin Pathol. 1994;47:961-963. Free Text Link
CASO 124
16 de mayo
Dra. Juanita Arango Abisaad. Residente de dermatología universidad CES. Dra. Vanessa Garcia Valencia. Residente de dermatopatología universidad CES
Dra. Luz Stella Abisaad. Dermatóloga Universidad CES. Medellín, Colombia.
Dra. Camila Montoya. Patóloga- Dermatopatóloga. MSPBS. Asunción, Paraguay.
Mujer de 30 años con pápula única y asintomática en glúteo izquierdo de 1 año y medio de evolución. A la dermatoscopia se observan vasos radiales con estructuras blanquecinas redondeadas y umbilicación central.
¿Con la imagen clínica, dermatoscópica e histológica, cuál es el diagnóstico más probable?
A- Nevus intradérmico
B- Verruga viral
C- Queratosis seborreica irritada
D- Molusco contagioso
Solución y cierre del caso 2 de junio
![]() F1 | ![]() F2 | ![]() F3 |
|---|---|---|
![]() F4 | ![]() F5 | ![]() F6 |
![]() F7HE / PAS / TRICRÓMICO | ![]() F8By Dr Graham Beards at en.wikipedia, CC BY-SA 3.0< |
Respuestas 1ra parte - Clínica / Dermatoscópica
Molusco contagioso Fernando Cabo Gómez
Nevus intradérmico Jorge Calderón Gómez
Un poroma también podría ser
Molusco contagioso Juan Manuel González Calle
Molusco contagioso Sonia Tello
Molusco contagioso Carlos Cortés Caballero
Molusco contagioso Alberto Erazo
Molusco contagioso Jaime Campuzano
Molusco contagioso Luisa Silva
Molusco contagioso Nancy Grandez
Molusco contagioso Paola Prieto Pérez
Molusco contagioso Marco Alfonso Nieto Garcia
Q. Seborreica Irritada Anónimo
Molusco contagioso David Londoño Henao
Molusco contagioso Esther Mariela Estrada
Molusco contagioso Eduardo Garzón Aldas
Molusco contagioso Guimar Jiménez
Molusco contagioso Abril Trejo
Molusco contagioso Rolando Hernández Pérez
Clínicamente y dermatoscopicamente corresponde a un molusco
Molusco contagioso Adriana Balza Haddad
Respuestas 2da parte - Histología
Molusco contagioso Guillermo Ramos
Molusco contagioso Thiago Lenoir da Silva
Molusco contagioso Beatriz di Martino
Molusco contagioso Natalia Rodríguez
Molusco contagioso Carlos Barria
Molusco contagioso Sonia Tello
Molusco contagioso Ruth Estrada
Molusco contagioso María tibaduiza
Molusco contagioso Fernando Cabo Gómez
Molusco contagioso Jaime Soto
Molusco contagioso Ivette de Sanctis
Molusco contagioso Regina Barros Domíngues
Molusco contagioso María del Consuelo Gómez Y.
Molusco contagioso Xiomara Cuadros
Molusco contagioso Alberto Erazo
Molusco contagioso Jaime Campuzano
Molusco contagioso Alicia Benavides
Molusco contagioso Paola Prieto Pérez
Molusco contagioso Sabrina Viviana Herrera
Molusco contagioso Soledad Machado
Molusco contagioso Francisco Javier Merino R.
Molusco contagioso Alexander Gutiérrez
Molusco contagioso Mayra Carrijo-Rochael
Molusco contagioso Luciana Battipiede
Molusco contagioso Elena Gallego Domínguez
Molusco contagioso Eduardo Garzón Aldas
Molusco contagioso María Gloria Mendoza de S.
Molusco contagioso Daniel Cabral
Molusco contagioso María del Valle Centeno
Molusco contagioso Marco Alfonso Nieto
Molusco contagioso Clara Jaramillo
Respuesta
D. MOLUSCO CONTAGIOSO
Infección autolimitada descrita por Thomas Bateman (1814), causada por un ADN virus de doble cadena (F8), integrante del grupo Poxvirus (viruela, nódulo del ordeñador y nódulo de Orf). Se presenta con mayor frecuencia en niños, pudiendo también afectar adultos y pacientes inmunodeprimidos, especialmente en asociación con VIH.1 La transmisión se da por el contacto con fómites o con piel infectada bien sea por vía sexual, no sexual o por autoinoculación.1 El período de incubación es de 2-6 semanas. Su replicación se efectúa únicamente en el citoplasma de los queratinocitos, por lo que la infección se limita a la epidermis.1,2
El virus del molusco contagioso produce proteínas que modulan y alteran la actividad del factor nuclear kB (NF-kB) lo que permite la evasión de la respuesta inmune innata y adaptativa del huésped y contribuye a la persistencia de las lesiones cutáneas.2
El diagnóstico suele ser clínico, encontrándose habitualmente una lesión cupuliforme, firme, perlada, con una coloración que puede ser blanquecina, rosada o normocrómica, y una umbilicación central por la cual se puede extraer material similar al queso. Aunque suelen ser múltiples, en ocasiones pueden presentarse lesiones atípicas, solitarias, sin umbilicación central o con eccema alrededor que pueden dificultar el diagnóstico clínico, requiriendo estudio histopatológico, como en este caso (F1).
Entre los hallazgos característicos a la dermatoscopia está un orificio central con una estructura amarilla blanquecina multilobular rodeada de vasos radiales. También se describen estructuras blancas que pueden ser redondeadas, las cuales se correlacionan con la hiperplasia epidérmica endofítica lobulada (F2).
El estudio histopatológico es diagnóstico. Se observa una lesión en forma de copa (F3) con lóbulos invertidos con abundantes queratinocitos grandes, de citoplasma amplio con inclusiones virales en su interior conocidas como cuerpos de Henderson-Paterson y un núcleo periférico. En la capa granular (F4), los cuerpos se vuelven cada vez más basofílicos y ocupan la totalidad de la célula (F5-7). La epidermis cercana exhibe acantosis marcada (F6). 2
BIBLIOGRAFÍA
-
Meza-Romero R, Navarrete-Dechent C, Downey C. Molluscum contagiosum: an update and review of new perspectives in etiology, diagnosis, and treatment. Clin Cosmet Investig Dermatol. 2019 May;12:373–81. Free Text Link
-
Badri T, Gandhi GR. Molluscum Contagiosum. [Updated 2021 Mar 21]. In: StatPearls [Internet]. Treasure Island (FL): StatPearls Publishing; 2021 Jan-. Free Text Link
-
Rodríguez, G. Arenas, D. Molusco contagioso. Rev Asoc Colomb Dermatol. 2017 (octubre - diciembre); 25(4):304-313. Free Tex Link
CASO 123
26 de abril
Dr. Reinhard Rodríguez. Residente dermatopatología. Dr. Sneider Torres Soto, Dra. Carolina Mesa Mesa. Residentes de dermatología. Universidad CES.
Dra Ana Cristina Ruiz. Profesora Programa de Dermatopatología, Universidad CES. Medellín, Colombia.
Dra. Camila Montoya. Patóloga- Dermatopatóloga. MSPBS. Asunción, Paraguay.
Mujer, 34 años. Placa anular en mano izquierda de una semana de evolución.
Con los datos clínicos e histológicas suministrados, ¿cuál cree usted es el diagnóstico más probable?
A- Infección por micobacterias
B- Loxoscelismo cutáneo
C- Nódulo del ordeñador / Orf
D- Ántrax – Carbunco
E- Espororotricosis
Segunda parte (histología) 23 abril / Solución y cierre del caso 2 de mayo
![]() F1 | ![]() F2 | ![]() F3 |
|---|---|---|
![]() F4 | ![]() F5 | ![]() F6 |
![]() F7 | ![]() F8 | ![]() F9 |
![]() F10By Dr Graham Beards at en.wikipedia, CC BY-SA 4.0, https://commons.wikimedia.org/w/index.php?curid=36392524 |
Respuestas 1ra parte - Clínica
Nódulo del ordeñador / Orf Vanessa García
Nódulo del ordeñador / Orf Fernando Cabo Gómez
Nódulo del ordeñador / Orf Patrick Agostini
Nódulo del ordeñador / Orf Juan Eduardo Rocha Aguirre
Esporotricosis Lizza Paz
Loxoscelismo cutáneo Juan David Ruiz
Nódulo del ordeñador / Orf Libia Jimenez Jimenez
Loxoscelismo cutáneo Enrique Bellolio
Nódulo del ordeñador / Orf Regina Barros Domíngues
Nódulo del ordeñador / Orf Elizabeth Milena Arciniegas
Nódulo del ordeñador / Orf Jaime Campuzano
La lesión que se observa es una pápula elevada y quizá ayudaría saber a que se dedica está persona
Nódulo del ordeñador / Orf Mafe tibaduiza
Esporotricosis Paola Carolina Suárez Granados
Nódulo del ordeñador / Orf Luciana Battipiedi
Nódulo del ordeñador / Orf Elena Gallego Domínguez
Nódulo del ordeñador / Orf Esther Mariela Estrada
Carbunco Olga Carolina Ochoa de Armas
Nódulo del ordeñador / Orf María del Consuelo Gómez Y.
Nódulo del ordeñador / Orf Verónica Posso
Respuestas 2da parte - Histología
Nódulo del ordeñador / Orf Juan David Ruiz
Orf Aloisio Gamonal
Esporotricosis Mónica Gaviria
Nódulo del ordeñador / Orf Juan Carlos Garcés
Orf Chester Nimitz
Nódulo del ordeñador / Orf Daniela María Berroeta M.
Esporotricosis Juan Manuel González
Esporotricosis Carlos Barria
Äntrax - Carbunco Jaime Arturo Mejía
Nódulo del ordeñador / Orf Fernando Cabo Gómez
Nódulo del ordeñador / Orf Elena Gallego Domínguez
Nódulo del ordeñador / Orf Mayra Carrijo Rochael
Nódulo del ordeñador / Orf Elizabeth Ball
Nódulo del ordeñador / Orf Enrique Bellolio
Esporotricosis Jaime Campuzano
Los microorganismos intracelular por Sporothrix schenckii
Esporotricosis Alicia Benavides Mendoza
Nódulo del ordeñador / Orf Melisa Alejandra Quintero P.
Nódulo del ordeñador / Orf Esther Mariela Estrada
Nódulo del ordeñador / Orf Sabrina Viviana Herrera
Nódulo del ordeñador / Orf Eduardo Garzón Aldás
Nódulo del ordeñador / Orf Víctor León
Esporotricosis Juan Carlos Jaimes Ramírez
Inclusiones eosinofílicas intracitoplasmáticas
Nódulo del ordeñador / Orf Roy García
Nódulo del ordeñador / Orf Guillermo Ramos
Nódulo del ordeñador / Orf Abril Trejo
Respuesta
B. NÓDULO DEL ORDEÑADOR / ORF
Este es un caso interesante en el que inicialmente se pensó en esporotricosis o en una infección por micobacterias, realizándose una biopsia de la lesión. En la misma se observaron los hallazgos característicos del nódulo del ordeñador/ enfermedad de Orf .
Después del diagnóstico histológico se interrogó nuevamente a la paciente, quien comentó haber tenido días antes contacto indirecto con ganado vacuno en una granja que administraba su hermano, de profesión veterinario.
El nódulo del ordeñador es una enfermedad infectocontagiosa ocupacional, que ocurre en personas que tienen contacto con vacas ocasionada por un poxvirus (F10). No obstante, también se han descrito relacionado con fómites, como en este caso.
Clínicamente se presentan como lesiones que ocurren luego de 5 a 14 días posterior al contacto, las cuales evolucionan a pápulas o nódulos que finalmente se ulceran dejando una costra central (F1). Las lesiones son autolimitadas, resolviendo entre 6 a 12 semanas, dejando una cicatriz, como sucedió en esta paciente (F9).
Los hallazgos histopatológicos difieren de acuerdo con el estadio clínico de la lesión. Se caracteriza por epidermis con hiperqueratosis, acantosis y papilomatosis (F2), asociado a severa espongiosis con formación de vesículas similares a las observadas en procesos eczematosos agudos (F3-4). De forma variable se puede observar ulceración, necrosis epidérmica, edema intracelular y degeneración vacuolar del estrato basal.
En las fases intermedias a tardías es posible identificar cuerpos de inclusión eosinofílicos en el citoplasma de los queratinocitos edematosos, siendo este un hallazgo patognomónico de las infecciones por virus de la familia poxviridae (F5-6).
En dermis se observa un infiltrado inflamatorio denso de predominio linfohistiocitario acompañado de forma variable por plasmocitos y eosinófilos. En este caso se observó un hallazgo no descrito en esta entidad como fue la presencia de un vaso trombosado en medio de la dermis (F7-8). Las coloraciones de ZN, PAS D y plata metenamina fueron negativas.
El nódulo de Orf es clínica e histológicamente muy similar al nódulo del ordeñador, siendo el de Orf transmitido por contacto con ovejas.
En conclusión,
- El diagnóstico del nódulo del ordeñador se basa en la historia clínica, antecedentes epidemiológicos y hallazgos histológicos.
- Sin embargo, para confirmación del agente patógeno se requiere de estudios de hibridación in situ o PCR, ya que todos los virus pertenecientes a la familia poxviridae manifiestan el mismo tipo de inclusión, aún con microscopía electrónica (F10).
- Las tinciones especiales (PM, PAS-D y ZN) negativas ayudan a descartar los posibles diagnósticos diferenciales.
BIBLIOGRAFÍA
-
Poudel GP, Agrawal S, Dhakal S. Milker's nodule: An under-reported and under-diagnosed occupational infection. Clin Case Rep. 2020 Apr 14;8(7):1162-1165. Free text link
-
Jayasree P, Kaliyadan F, Abraham R. Milker's Nodule. JAMA Dermatol. 2020 Jan 1;156(1):93. PubMed
-
Marckmann D, Frasnelli A. Milker's Nodule (Pseudocowpox) in a Female Patient Following a Calf Bite. Dtsch Arztebl Int. 2020 Dec 11;117(50):870. Free text link
-
Espósito ACC, Jorge MFS, Marques MEA, et al. Milker's nodules: classic histological findings. An Bras Dermatol. 2017 Nov-Dec;92(6):838-840. Free text link
-
Handler NS, Handler MZ, Rubins A, et al. Milker's nodule: an occupational infection and threat to the immunocompromised. J Eur Acad Dermatol Venereol. 2018 Apr;32(4):537-541. PubMed
CASO 122
16 de marzo
Dra Vanessa García - Dr. Javier Hernández. Residentes Dermatopatología, Universidad CES. Mdlln, Col.
Dra. Camila Montoya. Patóloga- Dermatopatóloga. MSPBS. Asunción, Paraguay.
Paciente masculino de 73 años quien presenta una pápula perlada con telangiectasias en la región malar derecha de 6 meses de evolución.
Con los datos clínicos suministrados y los hallazgos histológicos, ¿cuál cree usted es el diagnóstico más probable?
A- Carcinoma escamocelular de células claras
B- Carcinoma basocelular de células claras
C- Triquilemoma
D- Carcinoma sebáceo
Solución y cierre del caso 31 de marzo
![]() F1 | ![]() F2 | ![]() F3 |
|---|---|---|
![]() F4 | ![]() F5 | ![]() F6 |
![]() F7 | ![]() F8 PAS / PAS D | ![]() F9 IHQ BerEP4 / R. ANDRÓGENOS / EMA |
Respuesta
CBC/ células claras Juan Eduardo Rocha Aguirre
Izikson L, Bhan A, Zembowicz A. Androgen receptor expression helps to differentiate basal cell carcinoma from benign trichoblastic tumors. Am J Dermatopathol. 2005 Apr;27(2):91-5.
Carcinoma sebáceo Juan Manuel González
CBC/ células claras Jaime Arturo Mejía
CBC/ células claras María Isabel Moreno Vivanco
CBC/ células claras Liza Daniela Paz
CBC/ células claras Jaime Campuzano
CBC/ células claras Mónica Gaviria
CBC/ células claras Juan Carlos Garcés
Carcinoma sebáceo Anónimo
Carcinoma sebáceo Marcela Olaya
CBC/ células claras María Janeth Vargas
CBC/ células claras Juan Téllez
CBC/ células claras Roy García
CBC/ células claras Marcia Kibune
CBC/ células claras Soledad Machado
CBC/ células claras Marithe Gohe
Triquilemoma Carlos Barria
CBC/ células claras Elizabeth Ball
CBC/ células claras Esther Mariela Estrada
CEC/ células claras Elizabeth Milena Arciniegas
CBC/ células claras Thiago Lenoir da Silva
CBC/ células claras Luciana Battipiede
CBC/ células claras Romina Caycho
CBC/ células claras Guimar Jiménez
CBC/ células claras Gerardo Prada Chona
CBC/ células claras Enrique Bellolio
CBC/ células claras Anónimo
CBC/ células claras Uberto Gironzini
CBC/ células claras Esther Condori
CBC/ células claras Paola Carolina Suárez
CBC/ células claras Margarita Oliver
CBC/ células claras Elena Gallego
CBC/ células claras Claudia Maldonado
Carcinoma sebáceo Elizabeth Rodríguez P.
CBC/ células claras Mary Escarabay
CBC/ células claras Gonzalo Eguiguren
CBC/ células claras Margarita Kuri
Respuesta
B. CARCINOMA BASOCELULAR CON CÉLULAS CLARAS (CBC)
El carcinoma basocelular (CBC) es el tipo más frecuente de cáncer no melanoma de la piel (1). Clínicamente consiste en pápulas o nódulos brillantes y nacarados con ulceración o sangrado (2). Su localización más frecuente es en áreas fotoexpuestas como cabeza y cuello (1).
Parece ser que CBC surge de células pluripotenciales en la capa basal de la epidermis con amplia capacidad de diferenciación. Como consecuencia, existe una amplia variedad de subtipos histológicos, (4) siendo uno de ellos la de células claras (Barr y Williamson 1984) (2). Esta es una rara variante de CBC, con pocos casos reportados.
Histológicamente, este caso permite apreciar un CBC con dos componentes (F1); el primero conformado por nidos de células basaloides con un patrón convencional de palizada periférica, retracción del estroma, figuras mitóticas y células apoptóticas (F2, F3). El segundo por un componente de células claras que exhibe citoplasmas claros univacuolados (F4, F7). Ambos patrones histológicos se hallan bien definidos (F2), pero se entremezclan y forman zonas de transición en algunas áreas (F5, F6). Se realizaron estudios de inmunohistoquímica, observándose nidos de células tumorales reactivos para BER-EP4 y receptores de andrógenos y negativos para EMA (F9). Las tinciones especiales de histoquímica mostraron positividad para glucógeno con tinción de PAS, sensible a la diastasa (PAS-D) (F8).
El tratamiento y pronóstico es igual que el de un carcinoma basocelular convencional.
A - CARCINOMA ESCAMOCELULAR CON CÉLULAS CLARAS (INCORRECTO)
Se observan nidos con células claras asociados con áreas de diferenciación escamosa, focos de queratinización y perlas córneas; asimismo, no hay expresión del marcador BER-EP4.
C - TRIQUILEMOMA (INCORRECTO) (Ver caso 23).
D – CARCINOMA SEBÁCEO (INCORRECTO) (Ver caso 121)
BIBLIOGRAFÍA
-
Sarma DP, Olson D, Olivella J, et al. Clear cell Basal cell carcinoma. Patholog Res Int. 2011;2011:386921. Free Text Link
-
Forman SB, Ferringer TC. Clear-cell basal cell carcinoma: differentiation from other clear-cell tumors. Am J Dermatopathol. 2007;29(2):208-209. PubMed
-
Fernández-Aceñero MJ, Cenjor C, Córdova S. Clear cell basal cell carcinoma with pulmonary metastasis: case report and literature review. Am J Dermatopathol. 2011;33(4):379-382. PubMed
-
Kim DOY, Cho SB, Chung KY, et al. Clear cell basal cell carcinoma with sialomucin deposition. Yonsei Medical Journal. 2006;47(6):870–872. Free Text Link
CASO 121
16 de febrero
Dr. Juan Eduardo Rocha - Dr. Reinhard Rodríguez. Residentes Dermatopatología. Universidad CES. Mdlln, Col.
Dra. Camila Montoya. Patóloga-Dermatopatóloga. MSPBS. Asunción, Paraguay.
Caso y fotos clínicas cortesía Dra. Ana Milena Toro - María Cristina Trujillo. Dermatólogas UPB. Mdlln, Col
Paciente femenina de 77 años que presenta una lesión tumoral en el antebrazo derecho de 2 meses de evolución, con crecimiento rápido, dolorosa y de sangrado fácil.
Con los datos clínicos e histológicos suministrados ¿Cuál cree usted es el diagnóstico más probable?
A. Carcinoma basocelular con diferenciación sebácea
B. Adenoma sebáceo
C. Sebaceoma
D. Carcinoma sebáceo
Solución y cierre del caso 25 de febrero
![]() F1 | ![]() F2 | ![]() F3 |
|---|---|---|
![]() F4 | ![]() F5 | ![]() F6 |
![]() F7 | ![]() F8 | ![]() F9Antígeno epitelial de membrana |
![]() F10Antígeno epitelial de membrana |
Respuestas
Carcinoma sebáceo Jaime Campuzano
Carcinoma sebáceo Alicia Benavides Mendoza
Sebaceoma Anónimo
CBC/ diferenciación sebácea Milena Arciniegas
Sebaceoma Fernando Cabo Gómez
EMA positivo en sebocitos maduros y negativo en células germinales
Carcinoma sebáceo Soledad Machado
Carcinoma sebáceo Elena Gallego
Carcinoma sebáceo Kharla Pizarro
Sebaceoma Jaime Arturo Mejía
CBC/ diferenciación sebácea Gerardo Prada
Carcinoma sebáceo José Abraham Jaramillo O.
Carcinoma sebáceo Elizabeth Ball
Carcinoma sebáceo Vanessa García Valencia
CBC/ diferenciación sebácea María Isabel Moreno Vivanco
Carcinoma sebáceo Heliana Botello
Carcinoma sebáceo Mayra Rochael
Carcinoma sebáceo Mary Escarabay
CBC/ diferenciación sebácea Carlos Barria
Carcinoma sebáceo Sandra Quijano Moreno
Sería interesante ver la IHQ para adipofilina
Sebaceoma Jesús Cuevas Santos
Carcinoma sebáceo Graciela Carabajal
Sebaceoma Mónica Ruiz Ballón
Carcinoma sebáceo María del Mar Lorido
Carcinoma sebáceo Clara Jaramillo
Carcinoma sebáceo Marcia Kibune
Carcinoma sebáceo Marcela Olaya
Carcinoma sebáceo María de la Paz Rosas C.
Carcinoma sebáceo Carmen Camauta
Carcinoma sebáceo Diana Verónica Posso
Carcinoma sebáceo Esther Mariela Estrada
Solicitar tinción especial para lípidos
Carcinoma sebáceo Gonzalo Eguiguren
CBC/ diferenciación sebácea Bertha Yulieth Garzón Mora
Carcinoma sebáceo Sabrina Herrera
Respuesta
D. Carcinoma sebáceo (CS)
Se presenta usualmente en adultos, edad media de 60 a 70 años y predomino femenino 1. Puede ocurrir virtualmente en cualquier lugar donde se encuentren glándulas sebáceas. Sin embargo, el CS ocular y periocular es mucho más frecuente que su homólogo por fuera de cabeza y cuello. Este caso resalta por una presentación clínica inusualmente llamativa por su tamaño y localización (F1 y F2) 1.
Histológicamente, el CS se presenta como una neoplasia epitelial dispuesta en patrón lobular (F3 y F4), compuesta por células poligonales de aspecto basaloide con atipia citológica y elevado índice mitótico con mitosis atípicas (F7 y F8). El grado de diferenciación de esta neoplasia radica en la identificación de sebocitos maduros con su citoplasma multivacuolado característico y la presencia de ductos sebáceos en la lesión (F5 y F6). La marcación inmunohistoquímica con EMA permite identificar la diferenciación sebácea madura, como en este caso que muestra positividad en patrón microvesicular en los sebocitos tumorales (F9 y F10). Otros marcadores útiles para identificar diferenciación sebácea incluyen receptor de andrógenos y adipofilina 2, 3.
Cada vez se hace más importante identificar aquellos casos de CS extraocular asociados al síndrome de Muir–Torre, variante fenotípica del síndrome de Lynch que aumenta el riesgo de desarrollar neoplasias malignas 4,5.
A. Carcinoma basocelular con diferenciación sebácea: Histológicamente se distingue de este último por la ausencia de empalizada periférica, retracción epitelio-estromal y características nucleares. Sin embargo, puede resultar en un diagnóstico diferencial difícil en pequeñas biopsias, por lo que el uso de marcadores de inmunohistoquímica tipo BerEP4 pueden ser de utilidad.
B. Adenoma sebáceo: Se logra hacer el diagnóstico diferencial gracias a las características de neoplasia benigna que presenta esta lesión, ausentes en el CS.
C. Sebaceoma: Resulta ser un escenario similar a la opción anterior. No obstante, los sebaceomas pueden tener índices mitóticos ligeramente elevados sin considerarse atípico, por lo que siempre es recomendable evaluar los demás criterios de malignidad (patrón de infiltración, mitosis atípicas, necrosis) en una biopsia adecuada.
REFERENCIAS
-
Gaitán M, Trujillo MC, Toro AM, Restrepo R. Tumor exofítico en antebrazo. Revista de la Asociación Colombiana de Dermatología y Cirugía Dermatológica 23, no. 1 (2015): 77-79. Free text link
-
Boecker W, Reusch M, Mielke V, et al. Twenty-Eight Cases of Extraocular Sebaceous Carcinoma: A Correlative Clinicopathological and Immunohistochemical Analysis of Extraocular Sebaceous Carcinomas and Benign Sebaceous Gland Tumors. The American Journal of Dermatopathology 43.2 (2021): 93-102. Pubmed.
-
Plaza JA, Mackinnon A, Carrillo L, Prieto VG, Sangueza M, Suster S. Role of immunohistochemistry in the diagnosis of sebaceous carcinoma: a clinicopathologic and immunohistochemical study. Am J Dermatopathol. 2015 Nov;37(11):809-21. Pubmed
-
Flux K. Sebaceous Neoplasms. Surg Pathol Clin. 2017 Jun;10(2):367-382. Pubmed
-
Konstantinova AM, Kastnerova L, Michal M, Kolm I, Kazakov DV. Sebaceous Tumors of the Skin: A Study of 145 Lesions From 136 Patients Correlating Pathologic Features and DNA Mismatch Repair Staining Pattern. The American Journal of Dermatopathology. 2021 Mar 1;43(3):174-81. Pubmed
CASO 120
18 de enero
Dr. Reinhard Rodríguez y Dr. Javier Hernández. Residentes Dermatopatología, Universidad CES. Dra. Camila Montoya. Patóloga- Dermatopatóloga. MSPBS. Asunción, Paraguay.
Caso y fotos clínicas cortesía Dra. Carolina Velásquez. Profesora Dermatología Universidad CES. Mdlln, Col
Paciente masculino de 85 años quien presenta mácula hiperpigmentada en la frente.
¿Cuál cree usted es el diagnóstico más probable?
A. Queratosis actínica pigmentada
B. Lentigo solar
C. Nevus displásico
D. Lentigo maligno
Solución y cierre del caso 30 de enero
![]() F1 | ![]() F2 | ![]() F3 |
|---|---|---|
![]() F4 | ![]() F5 | ![]() F6 |
![]() F7 | ![]() F8 SOX10 | ![]() F9 SOX10 |
Respuestas
Lentigo solar Vanessa García Valencia
Lentigo maligno Ana Sanín
Lentigo solar Marco Mazzotta
Lentigo maligno Carlos Cortés Caballero
Lentigo solar Anónimo
Lentigo solar Carlos Barria
Lentigo maligno Sabrina Viviana Herrera
Lentigo solar Fernando Cabo Gómez
Con hiperplasia melanocítica actínica
Acant. Cel. grandes Graciela Carvajal
Q. A. pigmentada Gerardo Prada
Lentigo solar Jaime Arturo Mejía
Q. A. pigmentada Juan Manuel González Calle
Lentigo maligno Francisco Javier Merino
Lentigo solar Elizabeth Milena Arciniegas
Lentigo solar José Abraham Jaramillo
Lentigo solar Guimar Jiménez
Q. A. pigmentada Alicia Benavides Mendoza
Lentigo solar Esther Mariela Estrada
Lentigo solar Marcela Olaya Posada
Q. A. pigmentada Jaime Campuzano
Lentigo solar Víctor León
Lentigo solar Anónimo
Lentigo solar Anónimo
Lentigo solar Marcia Kibune
Lentigo solar María del Consuelo Gómez
Lentigo solar Fernando Brenner
Lentigo solar Gonzalo Eguiguren
Lentigo solar Mariano Jaramillo Dueñas
Lentigo solar Jaqueline Hernández
Respuesta
C. Lentigo solar (LS)
Es uno de los trastornos pigmentarios adquiridos más frecuentes, desencadenado por la exposición solar crónica y la contaminación medioambiental. Se observa frecuente en zonas fotoexpuestas como la cara, la región dorsal de las manos y la espalda, en pacientes de edad de ambos sexos y con fototipos claros (1). Su aparición en zonas no fotoexpuestas o edades más tempranas suele asociarse con síndromes hereditarios. Estudios han demostrado que la exposición crónica a los rayos UVB induce daño en el ADN de los queratinocitos los cuales incrementan la producción de citoquinas proinflamatorias (TNF-α) que lleva a la activación de los melanocitos periféricos, melanogénesis y pigmentación del estrato basal (2).
Clínicamente, se manifiesta como una mácula hiperpigmentada de bordes bien definidos, con una distribución homogénea del pigmento y discreto aumento del patrón reticulado. Es infrecuente la presencia de bordes activos, alteraciones en la distribución del pigmento o alteraciones vasculares. La dermatoscopia permite un adecuado seguimiento y detección temprana de cualquier anormalidad. Los LS suelen presentarse de forma múltiple, pudiendo exhibir distintos tamaños y colores, generalmente relacionados una piel con marcado fotodaño (F1), (1, 2).
En el estudio histológico, se observa una lesión de límites precisos, caracterizada por un aumento de la pigmentación basal y elongación de la red de crestas. En algunos casos se aprecia ligera acantosis y diversos grados de elastosis solar (F2-F4). Con mayor aumento se reconoce incremento en el número de melanocitos, los cuales se distribuyen en el estrato basal de manera individual, sin formación de nidos ni ascenso a estratos superiores de la epidermis. Los queratinocitos presentan aumento del pigmento, sin atipia citológica, ni elevación del índice mitótico o trastornos de la maduración. Algunos LS pueden exhibir queratinocitos con aumento de la relación núcleo-citoplasma, pudiendo solaparse con acantomas de células grandes, reforzando la idea de algunos autores de que ambas entidades corresponden a un mismo espectro de lesión. Con las tinciones de inmunohistoquímica con SOX10 se confirma el aumento de la densidad de los melanocitos sin formación de nidos ni evidencia de ascenso pagetoide significativo o un patrón confluente (2, 3). (F8 y F9).
Los LS presentan características histológicas distintas dependiendo del tiempo de evolución de la lesión. Las lesiones tempranas suelen no presentar la típica elongación de la red de crestas y un ligero aumento de la pigmentación. A medida que la lesión envejece se acentúan los cambios clásicos descritos y finalmente se pueden observar cambios regresivos como el infiltrado linfocítico similar a la queratosis liquenoide benigna (4).
A. Queratosis actínica pigmentada (QAP)(incorrecto): Es uno de los diagnósticos diferenciales más importantes. Clínicamente, la QAP se distingue por la presencia de descamación superficial y cambios vasculares que distan del aspecto usual de LS. Microscópicamente existen ciertas dificultades a la hora de distinguir los cambios displásicos del epitelio con los cambios asociados a la fotoexposición crónica, tanto en los queratinocitos como en los melanocitos. Una clave diagnóstica es que los cambios displásicos casi siempre se relacionan con trastornos en la maduración de la epidermis, por lo general con paraqueratosis e hipogranulosis. Además, la queratosis actínica pigmentada generalmente se asocia con atrofia epidérmica y no se relaciona con un aumento en el número de melanocitos. Los estudios de inmunohistoquímica con SOX10/P40 pueden ser útiles en casos de dificultad.
C. Nevus displásico(incorrecto): Se descarta fácilmente ya que la lesión no presenta nidos de melanocitos ni los cambios arquitecturales típicos.
D. Lentigo maligno (incorrecto): Ver caso 92
Bibliografia
-
Goorochurn R, Viennet C, Granger C, et al. Biological processes in solar lentigo: insights brought by experimental models. Exp Dermatol. 2016 Mar;25(3):174-7. Free text link
-
Imokawa G. Melanocyte Activation Mechanisms and Rational Therapeutic Treatments of Solar Lentigos. Int J Mol Sci. 2019 Jul 26;20(15):3666. Free text link
-
Black WH, Thareja SK, Blake BP, et al. Distinction of melanoma in situ from solar lentigo on sun-damaged skin using morphometrics and MITF immunohistochemistry. Am J Dermatopathol. 2011 Aug;33(6):573-8. Pubmed
-
Andersen WK, Labadie RR, Bhawan J. Histopathology of solar lentigines of the face: a quantitative study. J Am Acad Dermatol. 1997 Mar;36(3 Pt 1):444-7. Pubmed